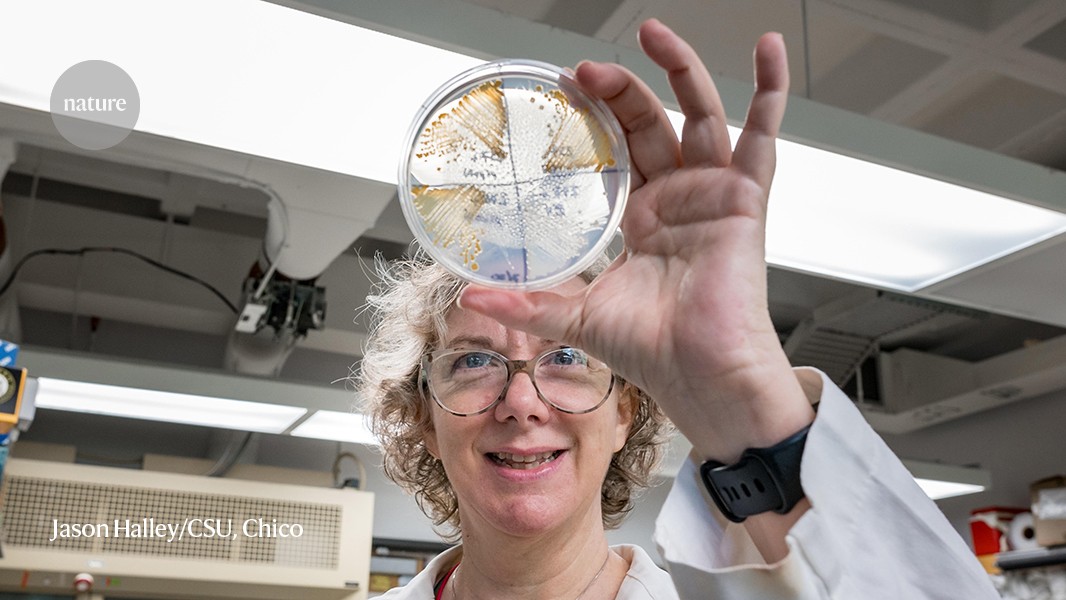
VADavisLab1's tweet card. Nature - In a scientific culture that eschews admitting failure, some researchers are staring it in the face — and finding success.

VA Davis Lab
@VADavisLab1
Our research focuses on Structure-processing-property relationships for nanomaterial dispersions and polymers , sustainability, and increasing STEM equity.
You might like
Opinions on this account are those of Dr. VA Davis and do not necessarily reflect those of others including Auburn University and funding agencies.
Looking forward to #acsspring2024 ! Check our latest work on : 3D printing MXene Inks- 3/17 8:30 am Hall B Rm 11; Importance of Science & Eng Fairs - 3/18 11:35 am; CNC Films 3/18 4:30 pm; Reprocessing Multilyer Polymers Poster M55 1:30 pm.
Excited to share our latest sustainability research! Cellulose Nanocrystals are a Renewable and Biocompatible Nanocarrier of Agrochemicals Directly to Plant Cells - Vinzant - Advanced Sustainable Systems - Wiley Online Library onlinelibrary.wiley.com/doi/10.1002/ad…
We are searching for someone like you! Apply today: auemployment.com/postings/41124

Excited & honored to be part of the SEC Academic Leadership Development Program! ocm.auburn.edu/newsroom/campu…
Interesting article about a rarely discussed topic. Failed PhD: how scientists have bounced back from doctoral setbacks nature.com/articles/d4158…
Proud of my colleague @ElizabethLipke Lipke and Yuan Tian for moving their technology towards commercialization. Two startups with Auburn connections collectively win $75K at Alabama Launchpad oanow.com/news/local/bus… via @oanow
The Brown lab is hiring! My lab is seeking a postdoctoral associate to work on projects developing fibrin-interfacing biomaterials for hemostasis, healing, and anti-thrombotic therapies. Interested applicants should send their CV to Dr. Brown at [email protected]
I am looking for one, possibly two post-docs with experience in polymer science. One position is joint with Yi lab, on multifunctional membranes. The other position requires experience in polymer chemistry and synthesis. Please send applications to my @TuftsEngineer email address
If you found this thread helpful and would like to learn a streamlined process to write papers that get published, this free training will be ideal! 👇✨ annaclemens.com/training?utm_s…
The call for papers is out. The Biophysicist will be publishing a special issue focused on effective mentoring for the next generation of biophysicists. Submissions due Jan 2024. biophysics.org/Portals/0/BPSA… #CottrellScholars @RCSA1
Proud of my amazing PhD students in @VADavisLab1 for leading 3 outreach activities in 8 days. They inspired both middle & high school teachers and students highlighting all the ways engineers positively impact the world! @AuburnEngineers @AUchemicaleng @COSAMOutreach




STEM is everywhere #ALSTEM Dept. of Homeland Security Designates Landscape Architecture a STEM Discipline – THE DIRT dirt.asla.org/2023/07/12/dep…
Especially true for those who went through the pandemic, lab shutdowns, quarantines & supply chain issues... My Ph.D. took a long time—and there’s no shame in that | Science | AAAS science.org/content/articl…
In light of today's Supreme Court ruling, Rice is more resolute than ever to pursue the excellence that a diverse student body brings to our community of scholars. The law may change, but our commitment to diversity will not. bit.ly/3PBrvAw

New @VADavisLab1 publication. Prediction of structural properties of activated carbons derived from ... sciencedirect.com/science/articl…
First article in Journal of Engineering Education! With collaborators @JoniLakin Leonard Taylor and Margaret Mastrogiovanni.onlinelibrary.wiley.com/doi/10.1002/je…
Looking Forward to Tomorrow. ~200 projects, ~170 judges, ~30 expo exhibits, and thousands of dollars in awards @AuburnU @Society4Science #ASEF2023

United States Trends
- 1. #BaddiesUSA 61.5K posts
- 2. Rams 29.6K posts
- 3. TOP CALL 3,395 posts
- 4. #LAShortnSweet 22.2K posts
- 5. Scotty 9,942 posts
- 6. Cowboys 101K posts
- 7. Eagles 141K posts
- 8. Chip Kelly 8,780 posts
- 9. #centralwOrldXmasXFreenBecky 282K posts
- 10. SAROCHA REBECCA DISNEY AT CTW 298K posts
- 11. sabrina 62.6K posts
- 12. #ITWelcomeToDerry 15.8K posts
- 13. Raiders 68K posts
- 14. Market Focus 2,245 posts
- 15. AI Alert 1,006 posts
- 16. Vin Diesel 1,317 posts
- 17. #RHOP 12.4K posts
- 18. Ahna 7,368 posts
- 19. Stacey 24.6K posts
- 20. Stafford 15.3K posts
Something went wrong.
Something went wrong.